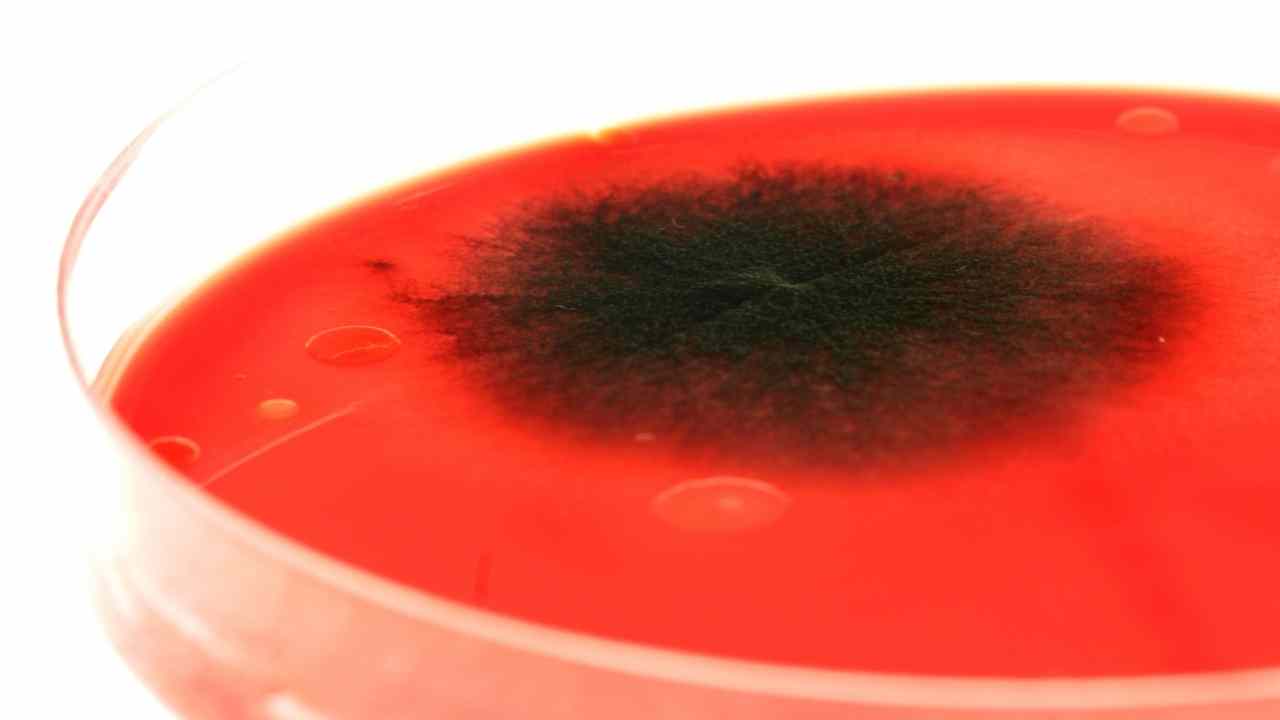

Em meio à pandemia de covid-19, uma nova preocupação para os profissionais de saúde. A Agência Nacional de Vigilância Sanitária fez um alerta sobre a descoberta de um fungo super resistente a medicamentos e que leva à morte em 60% dos casos. Esse é um possível primeiro caso de Candida auris no país. O fungo estava no cateter de um paciente com covid-19 internado em um hospital particular em Salvador.